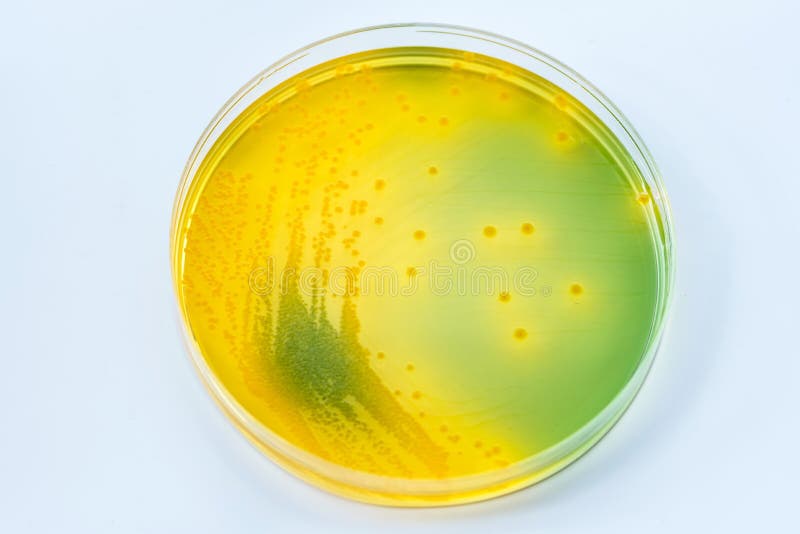

Бифидобактерии на грамм: микрофотографии и исследования











:max_bytes(150000):strip_icc()/bifidobacterium-5c38c295c9e77c00016a695b.jpg)

:max_bytes(150000):strip_icc()/e.coli_bacteria-596fcbfdb501e800112b7a72.jpg)










/imgs/2020/10/14/07/4175902/a1f5cb9553f63fc83ea9622323d10188d2669b9d.jpg)

























































Раздел: Другие животные